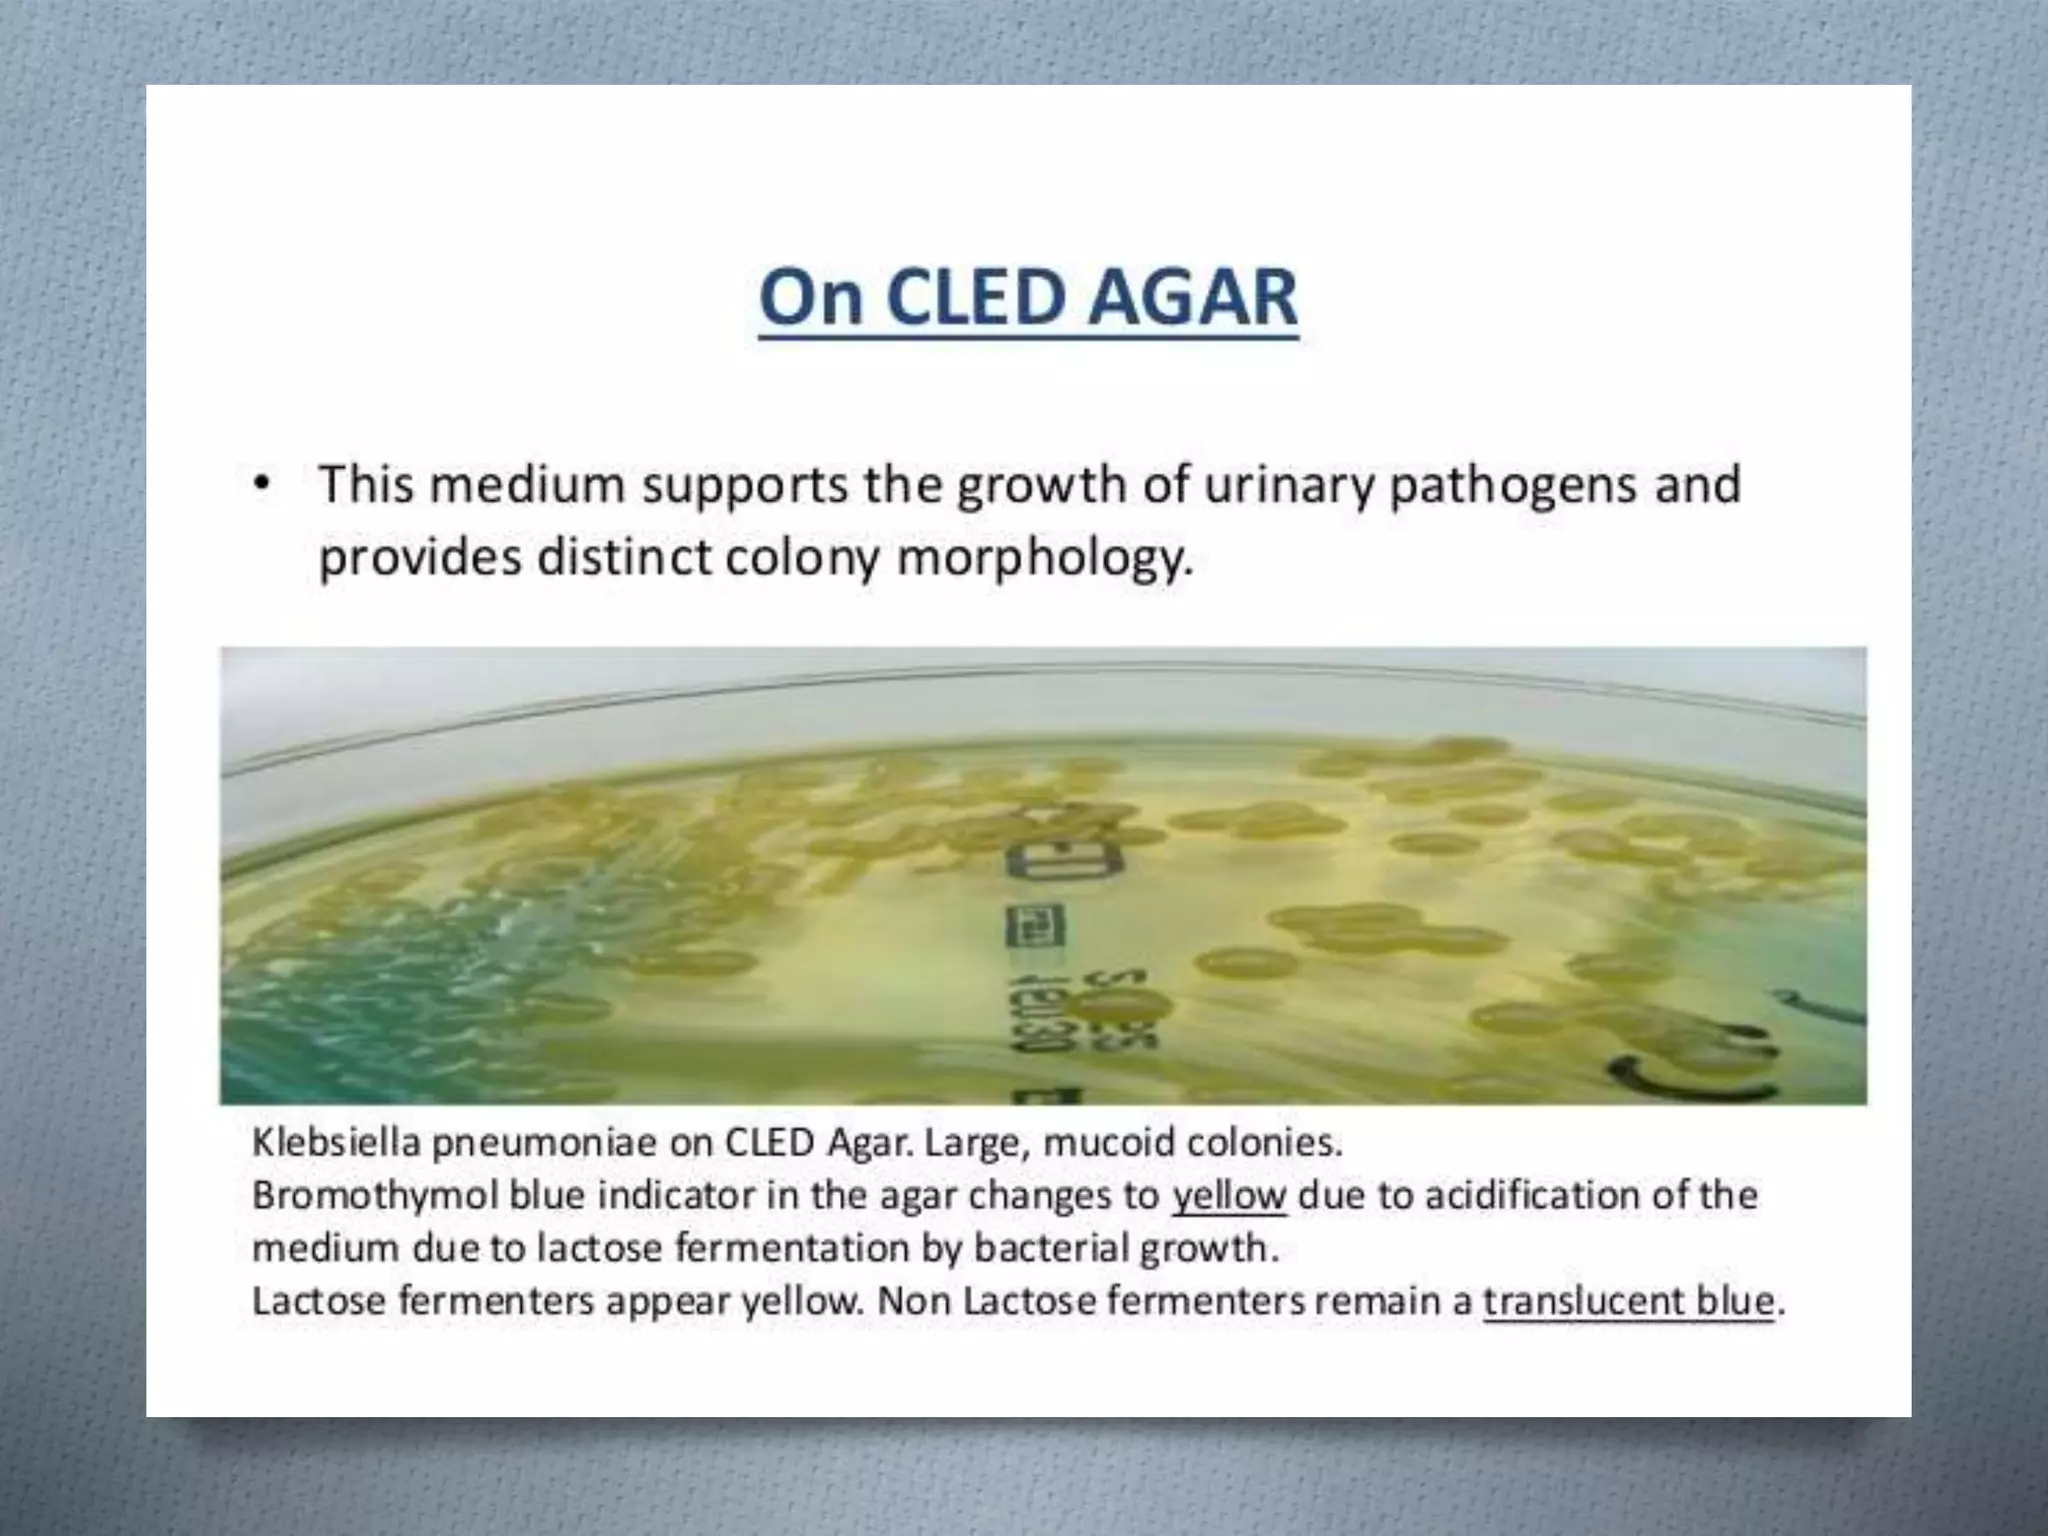
KLEBSIELLA SLIDESHARE PRESENTATION

This document summarizes information about the bacteria Klebsiella. It belongs to the genus Klebsiella within the family Enterobacteriaceae. Klebsiella is a facultative anaerobe found in the normal flora of humans. It can cause various opportunistic infections especially in immunocompromised individuals. While some Klebsiella infections respond to antibiotics, some strains have developed resistance. Carbapenem-resistant Klebsiella pneumoniae can be difficult to treat.